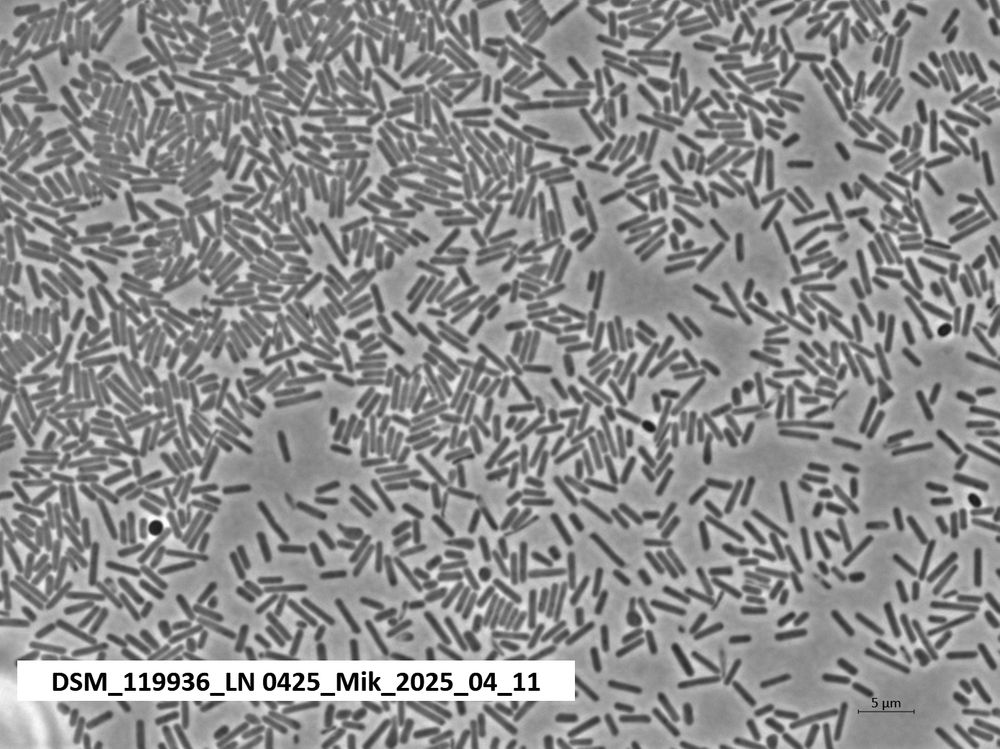

Leibniz Institute DSMZ
@leibniz-dsmz.bsky.social
890 followers
70 following
170 posts
Europe's leading bioresource center
research infrastructure
supplier of bioresources and scientific analyses
home of the DSMZ Digital Diversity Platform
www.dsmz.de
Posts
Media
Videos
Starter Packs
Reposted by Leibniz Institute DSMZ
Reposted by Leibniz Institute DSMZ
Reposted by Leibniz Institute DSMZ
Reposted by Leibniz Institute DSMZ
Reposted by Leibniz Institute DSMZ